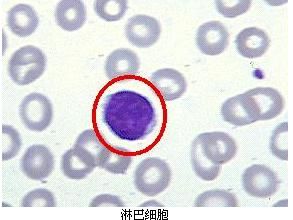
淋巴細胞
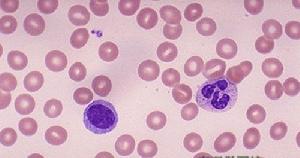
左側可見一正常的、成熟的淋巴細胞，右側是與其比較的分葉核嗜中性粒細胞。RBC是正常的淋巴細胞的23大小。
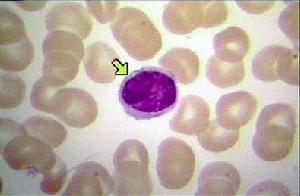
淋巴細胞

簡介
淋巴細胞
淋巴細胞淋巴細胞(lymphocyte)也稱淋巴球,由淋巴器官產生,機體免疫應答功能的重要細胞成分。在人體約占白細胞的20%-30%,圓形細胞核,細胞質很少。淋巴器官根據其發生和功能的差異,可分為中樞淋巴器官(又名初級淋巴器官)和周圍淋巴器官(又名次級淋巴器官)兩類。前者包括胸腺、腔上囊或其相當器官(有人認為在哺乳動物是骨髓)。它們無須抗原刺激即可不斷增殖淋巴細胞,成熟後將其轉送至周圍淋巴器官。後者包括脾、淋巴結等。成熟淋巴細胞需依賴抗原刺激而分化增殖,繼而發揮其免疫功能。
在光學顯微鏡下觀察淋巴細胞,按直徑不同區分為大(11~18微米)、中(7~11微米)、小(4~7微米)3種。周圍血液中主要是中小型細胞。血液中主要是小淋巴細胞和一定數量的中淋巴細胞。小淋巴細胞核相對很大,細胞質極少。核內染色質多,染色較深。核圓形深染,核周圍淺染,胞質藍灰色,某些疾病可以影響淋巴細胞數目的增減,如患肺結核時,淋巴細胞有顯著增加。
命名
 淋巴細胞
淋巴細胞1875年,Carl Ludwing觀察到人胸腺導管中的淋巴細胞。
1879年,Ehrlich被命名為淋巴細胞(lymphocyte)。
產生
淋巴細胞由淋巴器官產生,為機體免疫應答功能的重要細胞成分。淋巴器官根據其發生和功能的差異,可分為中樞淋巴器官(又名初級淋巴器官)和周圍淋巴器官(又名次級淋巴器官)兩類。前者包括胸腺、腔上囊或其相當器官(有人認為在哺乳動物是骨髓)。它們無須抗原刺激即可不斷增殖淋巴細胞,成熟後將其轉送至周圍淋巴器官。後者包括脾、淋巴結等。成熟淋巴細胞需依賴抗原刺激而分化增殖,繼而發揮其免疫功能。
體積
在光學顯微鏡下觀察淋巴細胞 ,按直徑不同區分為大(11—18微米)、中(7—11微米)、小(4—7微米)3種。周圍血液中主要是中小型細胞。
系統形態
 淋巴細胞
淋巴細胞1、原始淋巴細胞:胞體直徑10—18μm,圓或橢圓形。胞核大,位於中央或稍偏一側,圓或橢圓形、核染色質細緻,呈顆粒狀,但比原粒細胞稍粗,排列勻稱,核膜濃厚,界限清晰,核仁1—2個,胞質極少,呈淡藍色,透明,核周界明顯,無顆粒。
2、幼稚淋巴細胞:胞體直徑10—16μm,胞核圓或橢圓形,核仁模糊不清或消失,核染色質仍較細緻。胞質較少,淡藍色,偶有少許天青胺藍顆粒。
3、淋巴細胞:①大淋巴細胞:胞體圓形,直徑12—15μm,胞核橢圓形稍偏一側,核染色質排列緊密而均勻。胞質較多,呈清澈的淡藍色,可有少量大小不等的天青胺藍顆粒。②小淋巴細胞:胞體圓形,直徑6—9μm,胞核圓形或有小切跡,核染色質聚集緊密成大塊狀。胞質量很少,頗似裸核,如可見,呈淡藍色,一般無顆粒。
分類
按其發生遷移、表面分子和功能的不同可分為T細胞、B細胞和自然殺傷(NK)細胞。
T細胞
T細胞來源於骨髓的多能幹細胞(胚胎期則來源於卵黃囊和肝),T細胞是相當複雜的不均一體、又不斷在體內更新、在同一時間可以存在不同發育階段或功能的亞群,但目前(2011年)分類原則和命名比較混亂,尚未統一。按免疫應答中的功能不同,可將T細胞分成若干亞群,一致公認的有:輔助性T細胞(TH),具有協助體液免疫和細胞免疫的功能;抑制性T細胞(TS),具有抑制細胞免疫及體液免疫的功能;效應T細胞(TE),具有釋放淋巴因子的功能;細胞毒T細胞(TC),具有殺傷靶細胞的功能;遲發性變態反應T細胞(TD),有參與Ⅳ型變態反應的作用;放大T細胞(TA),可作用於TH和TS,有擴大免疫效果的作用;記憶T細胞(TM),有記憶特異性抗原刺激的作用。T細胞在體記憶體活的時間可數月至數年。其記憶細胞存活的時間則更長。
T細胞是淋巴細胞的主要組分,它具有多種生物學功能,如直接殺傷靶細胞,輔助或抑制B細胞產生抗體,對特異性抗原和促有絲分裂原的應答反應以及產生細胞因子等,是身體中抵禦疾病感染、腫瘤形成的英勇鬥士。T細胞產生的免疫應答是細胞免疫,細胞免疫的效應形式主要有兩種:與靶細胞特異性結合,破壞靶細胞膜,直接殺傷靶細胞;另一種是釋放淋巴因子,最終使免疫效應擴大和增強。
B淋巴細胞
B淋巴細胞亦可簡稱B細胞。來源於骨髓的多能幹細胞。在禽類是在法氏囊內發育生成,故又稱囊依賴淋巴細胞(bursadependentlymphocyte)/骨髓依賴性淋巴細胞簡稱:B細胞,是由骨髓中的淋巴幹細胞分化而來。與T淋巴細胞相比,它的體積略大。這種淋巴細胞受抗原刺激後,會增殖分化出大量漿細胞。漿細胞可合成和分泌抗體並在血液中循環。B細胞淋巴瘤是一種最常見的淋巴細胞白血病,有關這種疾病的研究不斷湧現。在哺乳類是在類囊結構的骨髓等組織中發育的。又稱骨髓依賴淋巴細胞。
從骨髓來的幹細胞或前B細胞,在遷入法氏囊或類囊器官後,逐步分化為有免疫潛能的B細胞。成熟的B細胞經外周血遷出,進入脾臟、淋巴結,主要分布於脾小結、脾索及淋巴小結、淋巴索及消化道黏膜下的淋巴小結中,受抗原刺激後,分化增殖為漿細胞,合成抗體,發揮體液免疫的功能。B細胞在骨髓和集合淋巴結中的數量較T細胞多,在血液和淋巴結中的數量比T細胞少,在胸導管中則更少,僅少數參加再循環。B細胞的細胞膜上有許多不同的標誌,主要是表面抗原及表面受體。這些表面標誌都是結合在細胞膜上的巨蛋白分子。B1細胞為T細胞非依賴性細胞。B2為T細胞依賴性細胞。B細胞在體記憶體活的時間較短,僅數天至數周,但其記憶細胞在體內可長期存在。
自然殺傷細胞
自然殺傷細胞是一種細胞質中具有大顆粒的細胞,也稱NK細胞。因為其非專一性的細胞毒殺作用而被命名。沒有T細胞B細胞所具的受體,不會進行受體的基因重組。但仍具有一些特殊受體,可以活化或抑制其作用。占循環中淋巴細胞族群的5-10%。和殺死腫瘤細胞有關,可利用分泌穿孔素及腫瘤壞死因子,摧毀目標細胞。
細胞採集
 淋巴細胞
淋巴細胞通常利用單核細胞在37℃和Ca2+ 存在條件下,能主動粘附在玻璃、塑膠、尼龍毛、棉花纖維或葡聚糖凝膠的特性,據此建立許從單核細胞懸液中去除單核細胞的方法,藉以獲得高純度的淋巴細胞群。
粘附貼壁法
將已製備的單個核細胞懸液傾於玻璃或塑膠平皿或扁平小瓶中,移至37℃溫箱靜置1h左右,單核細胞和粒細胞均貼於平皿壁上,而未貼壁的非粘附細胞幾乎為純淋巴細胞,繼用橡皮刮下貼壁的細胞即為純單核細胞群。因B細胞也有貼壁現象,用本法分離的淋巴細胞群中B細胞有所損失。
吸附柱過濾法
將單個核細胞懸液注入裝有玻璃纖維或葡聚糖凝膠SephadexG10的柱層中,凡有粘附能力的細胞絕部分被吸附而粘滯在柱層中,從柱上洗脫下來的細胞主要是淋巴細胞。此法簡單易行,對細胞極少損害。
磁鐵吸引法
利用單核細胞具有吞噬的特性,在單個核細胞懸液中加直徑為3μm的羰基鐵顆粒,置37℃溫箱內短時鏇轉搖動,待單核細胞充分吞噬羰基鐵顆粒後,用磁鐵將細胞吸至管底,上層液中含較純的淋巴細胞。
亞群分離
分離相當純化的淋巴細胞亞群是細胞免疫檢驗的基本技術。其原則是根據相應細胞的特性和不同的標誌加以選擇性純化。凡根據細胞的特性和標誌選擇純化所需細胞的方法是陽性選擇法;而選擇性去除不要的細胞,僅留下所需的細胞是為陰性選擇。常用以下幾方法:
E花環沉降法
本法是將淋巴細胞與一定比例的綿羊紅細胞混合,待淋巴細胞形成E花環後,繼用淋巴細胞分層液分離細胞。浮懸在分層界面而不形成E花環的群則富含B細胞,而沉降在管底的形成E花環的細胞用低滲法處理,使圍繞細胞周圍的綿羊紅細胞快速裂解,則獲得純的T細胞。
左側可見一正常的、成熟的淋巴細胞,右側是與其比較的分葉核嗜中性粒細胞。RBC是正常的淋巴細胞的2/3大小。
左側可見一正常的、成熟的淋巴細胞,右側是與其比較的分葉核嗜中性粒細胞。RBC是正常的淋巴細胞的2/3大小。尼龍毛分離法
 淋巴細胞
淋巴細胞本法利用B細胞和單核細胞具有易粘附於尼龍纖維表面的特性,可將T和B細胞分開。操作原則是取鬆散而經過處理的尼龍毛(聚醯胺纖維),均勻充填在內徑5—6nm的聚乙烯塑膠管(飲料管即可)內,經Hanks液浸透保溫,將單個核細胞懸液加入柱內,放37溫箱靜置1—2h。用預溫的含10%—20%小牛血清培養液灌洗,洗脫液內含有非粘附的T細胞,重複灌洗幾次以除去管內殘留的T細胞。再用冷或溫培養液邊沖邊洗邊擠壓塑膠管,此時洗脫液內富含B細胞。如此得到的T細胞純度在90%以上,B細胞純度可達80%。
親和板結合分離法
利用親和層析法分離淋巴細胞亞群,其原理是各種淋巴細胞亞群具有不同的抗原性,將相應抗體結合於塑膠平板上,繼加細胞懸液,凡抗原陽性的細胞則與相應抗體結合,抗原陰性的細胞可從未吸附的細胞懸液中獲取。同樣若用特異性抗原交聯在塑膠板上,則可分離得具有特異抗原受體的淋巴細胞。淋巴細胞受體與特異抗原或抗體接觸,可引起細胞激活,因此,凡欲去除細胞懸液內某一細胞亞群時,本法適用。
螢光激活細胞分離儀分離法
螢光激活細胞分離儀(fluorescenceactivatedcellsorter)主要由4部分組成:①細胞流動系統及氣壓流速控制系統,②雷射系統,③檢測與訊號處理系統,④細胞分選系統。其主要原理是細胞經螢光染色後,通過高速流動系統,細胞排成單行,逐個流經檢測區進行測定。
數量計算
成人淋巴細胞約占白細胞的1/4,為人體主要的免疫活性細胞。淋巴細胞分為B淋巴細胞和T淋巴細胞,此外還有少數自然殺傷細胞(NK細胞)、裸細胞(N細胞)、雙標誌細胞(D細胞)等,觀察淋巴細胞的數量變化,有助於了解機體的免疫功能狀態。它的測定也是臨床血細胞分析的常規內容。
血細胞自動分析儀法正常參考值:成年男性:0.7—5.3×109 /L;成年女性:0.7—5.6×109 /L。
臨床意義
淋巴細胞計數的生理變化
1、升高:與正常成年人比較,嬰兒約高100%,4~10歲兒童約高15%,吸菸者約高15%,黑人種族約高15%,晝夜律晚上約高15%,高海拔約高14%,婦女月經期約高5%。
2、降低:妊娠約低15%,劇烈的體育鍛鍊約低30%。
淋巴細胞
淋巴細胞藥物影響對淋巴細胞計數的影響
1、增加:對麻醉藥成癮者常有絕對的或相對的增加。秋水仙鹼和煙醯胺可致淋巴細胞絕對增加。如用煙醯胺後4小時上升25%,24小時上升40%。灰黃黴素等則引起相對增加。氨基水楊酸可產生傳染性單核細胞增多症樣綜合症。二硫化碳中毒時可輕度增高。氯磺丙脲致輕度增加,但無臨床症象。左鏇多巴致淋巴細胞增加伴溶血性貧血。
2、減少:免疫抑制劑可引起不同程度的減少。用促皮質素2小時發生明顯減少。瘤可寧可明顯減低淋巴細胞。鋰可能具內分泌作用,而苯妥英鈉則減少DNA合成,均致淋巴細胞減少。
病理變化
一)增多
1)某些病毒或細菌所致的急性傳染病,如風疹、流行性腮腺炎、傳染性淋巴細胞增多症、傳染性單核細胞增多症等。百日咳時淋巴細胞有數常明顯增多。
2)某些慢性感染:如結核病時淋巴細胞常增多,但白細胞總數一般仍可在正常值範圍內。
3)器官移植術後如發生排異反應時,特別是於排異前期,淋巴細胞數常出現增高。
4)淋巴細胞性白血病、白血性淋巴肉瘤時。
5)再生障礙性貧血、粒細胞缺乏症時,由於中性粒細胞顯著減少,導致淋巴細胞百分比相對增高,此時稱為淋巴細胞相對增多。
二)減少
主要見於接觸放射線及套用腎上腺皮質激素或促腎上腺皮質激素時。另外惡性腫瘤、何杰金氏病、腎上腺機能亢進、脊髓灰質炎、糖尿病酸中毒、急性闌尾炎、肺炎及先天性兒童淋巴細胞缺乏症均可出現淋巴細胞減少。
相關研究
正反作用
2011年初,復旦大學上海醫學院免疫學系儲以微教授課題組經研究發現,有一種從細菌中提取的名叫“BLP”的細菌脂蛋白,一旦與存在於T淋巴細胞表面的TLR-2受體“一對一配接”後,可以調動一群具有殺傷性T淋巴細胞明顯增強其殺傷癌細胞的能力,同時,這種“一對一配接”還可以削弱和抑制另外一群調節性T淋巴細胞“保護癌細胞”的能力。上述成果已發表在免疫學專業權威雜誌《免疫學期刊》(JournalofImmunology)上 。
愛滋病相關
人類淋巴細胞內的免疫蛋白質“APOBEC3”會與愛滋病病毒製造的特殊蛋白質“VIF”結合,從而難以發揮免疫作用,使人體在愛滋病病毒面前缺乏免疫力。研究人員分析“APOBEC3”結構後發現,這種蛋白質的凹陷結構是使它與“Vif”蛋白質結合的關鍵。研究人員認為,如果能找到可嵌入這種凹陷結構的化合物,就能防止“APOBEC3”與“Vif”結合,從而保持其正常的免疫作用,遏制愛滋病病毒增殖。研究人員表示下一步將尋找能與凹陷結構結合的化合物 。

